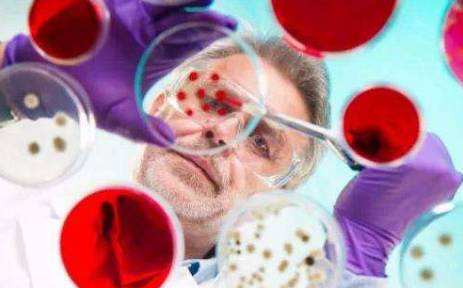
最近的外国奶粉安全吗,疫情荷兰进口的奶粉安全吗

中国奶粉行业正经历一轮新的洗牌,消费者可以选择更多优质优价奶粉的同时,仍有一部分宝妈们选择海淘或代购进口奶粉。然而,海外的奶粉真的安全吗?答案是未必。
近日,有产地来自美国、法国、爱尔兰的奶粉品牌被爆出疑似感染沙门氏菌,其中,产自爱尔兰、疑似感染沙门氏菌的奶粉已经出口至德国、荷兰、挪威、波兰等多个国家。

海外多产地爆发“毒奶粉”
据欧盟食品饲料快速预警系统(RASFF)通报预警显示,爱尔兰婴幼儿配方奶粉疑似感染沙门氏菌。据RASFF的评定,这起沙门氏菌污染事件被定性为“严重”事件。RASFF没有披露有关奶粉的品牌或生产商名称,也并不清楚有关奶粉是否被分销。
值得一提的是,上述事件是在7月27日由法国方面发现,并在欧盟发出预警。紧接着,爱尔兰于7月28日发现上述问题。7月30日,挪威发现问题并发布预警。
事实上,自去年至今,海外市场曾爆出多起奶粉感染沙门氏菌事件。
2017年10月份,来自法国的全球第二大乳企兰特黎斯集团也卷入沙门氏菌丑闻,该事件席卷全球80多个国家和地区,涉及1万多吨奶粉受污染,导致各主要国家禁止进口该公司奶粉。
另外,7月14日,美国疾病控制和预防中心的数据显示,美国已有33个州出现了沙门氏菌疫情,造成100人感染,其中30人住院治疗。
7月24日,美国食品和药物管理局(FDA)表示,怀疑最近一系列关于沙门氏菌导致食品召回事件与一家乳清供应商有关,并警告称未来几天可能会召回更多产品。
虽然上述受到污染的大部分奶粉品牌没有通过一般贸易进入中国市场,但是,每年通过跨境购、海淘、代购等方式进入我国的奶粉仍大量存在,因此,海外受污染奶粉也给这部分消费者带来安全隐患。
对此,中国食品产业分析师朱丹蓬表示,最近一年来,很多洋奶粉出现问题。“国内的消费者已经从过去盲目的崇拜洋奶粉,转换到可以科学的判断奶粉品牌、品质,消费也变得理性。”

民族品牌崛起洋奶粉神话褪色
事实上,除了上述奶粉受污染存在安全隐患外,上个月,荷兰皇家菲仕兰旗下的婴幼儿奶粉品牌美素佳儿也被媒体曝光,其奶粉在水里不能溶解。
据媒体报道,韩先生两个月前在苏宁易购买了3罐荷兰进口的美素佳儿金装奶粉。当他像往常一样冲泡时,发现奶粉在水里不能溶解,散发着一股异味。韩先生联系美素佳儿奶粉的进口商菲仕兰食品贸易(上海)有限公司,该公司的一位总监表示,韩先生买的奶粉是正品,质量也是有保障的。至于韩先生现在遇到的这些问题,目前公司也在寻找原因之中。
事实上,伴随着洋奶粉问题不断爆发,洋奶粉在消费者心目中的光环也逐渐褪色。另外,消费者对于民族品牌的信任度在不断提升。
据国家监督抽检显示:婴幼儿配方乳粉合格率:2014年98.3%,2015年98.9%,2016年98.7%,2017年1-11月份99.72%。乳制品合格率:2014年99.3%,2015年99.5%,2016年99.6%,2017年前三季度99.6%。婴幼儿配方乳粉、乳制品在国家食品药品监管总局监测的32大类食品中,合格率是最高的。
上述数据的背后,消费者开始追捧民族奶粉品牌,而受益于量价的提升,部分民族品牌的销售业绩也在不断增长。为此,乳企们纷纷定下目标:飞鹤2018年的目标是突破100亿元,而这个数字将与惠氏、达能等外资品牌的销售量十分接近;澳优的目标是60亿元;君乐宝透露的信息是,单一奶粉业务目标已从40亿元调整至50亿元。
(二三里实习编辑 王云颖)

来源:聊沈